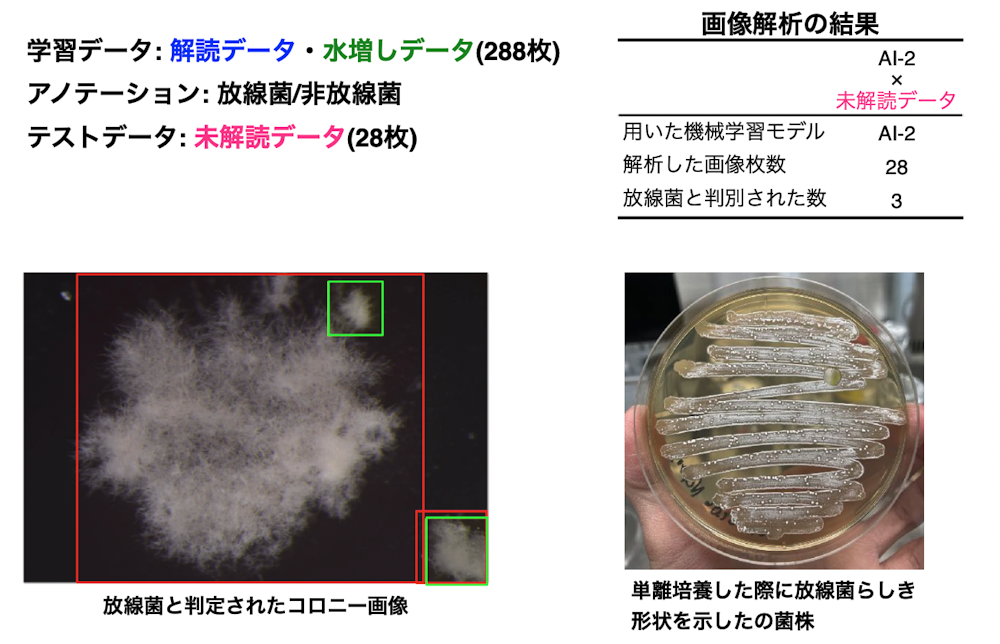
image1 2

このページでは、Humanome Eyes(以下「Eyes」)を実際にお使いいただいているユーザーの皆様へのインタビューをご紹介します。使ってみてどのように感じたか? など、率直な意見やご感想についてお伺いしています。
ご利用をお考えのお客様の参考になりますと幸いです。
お話しいただいた方

津田 賢太郎さん
東京都立大学理学部生命科学科1年
三田国際学園高等学校メディカルサイエンステクノロジーコース(MST)を2023年3月に卒業。高校在学中は「画像解析技術を用いた抗生物質生産菌単離法の開発」というテーマで、画像から放線菌を判別する研究に取り組んでいた。本研究において、高校生国際シンポジウム・生物部門で優秀賞を受賞、第96回日本薬理学会年会・第43回日本臨床薬理学会学術総会内セッション「探せ!ミライのお薬博士!やくりンピック」にて招待講演などの成果をあげている。
インタビュー
AIでコロニーの中身を判別する
ヒューマノーム研究所(以下「HNL」):
自己紹介をお願いします。
津田賢太郎さん(以下「津田」):
津田賢太郎です。三田国際学園高等学校で辻先生(津田さんの指導教官)にお世話になり、紹介を受けてEyesを使わせていただきました。
HNL:
無事大学への進学も決まったとのことで、おめでとうございます!
津田:
ありがとうございます。今年の4月から、東京都立大学の理学部生命科学科で学ぶ予定です。(注:このインタビューは2023年3月に実施しています)
メインで学ぶのは生物系ですが、Eyesを利用したことで情報系にも興味を持っていて、バイオインフォマティクスもできるといいなと思っています。
HNL:
素晴らしい!!好きな科目はありますか?
津田:
生物が好きですね。
辻先生(以下「辻」):
学会で招待公演で発表してたりしたよね?
津田:
はい。日本薬理学会の中高生発表に招待公演として発表させていただきました。
今日は僕の研究についても紹介させてください。
僕は「画像解析技術を用いた抗生物質生産菌単離法の開発」というテーマで、放線菌に焦点を当てて研究を進めていました。
放線菌はこれまで発見された抗生物質の半分以上を生産していることで有名ですが、近年、新しい抗生物質の発見が減少していることが問題としてあげられています。
そこで僕は新しい抗生物質を発見するには新しい放線菌を見つけるのが早いのでは?と考えて、新しい放線菌を探索する方法を考えました。この研究では、単離の段階に注目して、放線菌らしいコロニーをピックアップして、コロニーが放線菌かどうかについて画像で判別しました。
この画像から判別する部分でEyesを用いて、アノテーション・学習を行いました。

集めた株数が多くなかったので、フィルタをかけたりすることでデータを水増しし、16枚の画像データから272枚の画像データにした上でアノテーションを行いました。
今回の研究では、「放線菌かそれ以外かを判別するAI」「7種類の菌を判別するAI」をつくってみました。
最初の「放線菌かそれ以外かを判別するAI」についてですが、AIを作成した後に、解読済みデータ(放線菌であるかどうかがわかっている画像)で予測を試したところ、正確に判別することができました。
また、学習データとは全く別の未解読データ(放線菌か否かがわかっていない画像)で放線菌と判定された株を培養した際、その株は放線菌らしき形状を示したので、正しく判定できているように見えました。
HNL:
すごい!驚きです。予測と実際の結果がちゃんと結びついてますね。
津田:
つづいて「7種類のそれぞれの菌を判別するAI」についても試してみました。
ただ、こちらに関しては、放線菌は過不足なく正しく判定されていたものの、他の菌種はうまく判定できないものもありました。
正しく判定されなかったものは、元のデータが3株しかなかったことや、他の微生物と同じような形をしていたのでわからなかったのかもしれないです。
7種類すべての菌についてEyesを使ってアノテーションして評価まで実施したのですが、その中でも放線菌は精度よく判別できたかと思います。
HNL:
そもそも、なぜ放線菌の研究をやろうとしたんですか?
津田:
MST(「メディカルサイエンステクノロジーコース」の略。研究活動に積極的に取り組むコース。)に入った時に先輩方の研究紹介を聞く機会がありました。いろんな研究があった中で、抗生物質を生産する微生物というものがあるところや抗生物質が微生物からできることに驚いて、興味を持ったことがきっかけです。
HNL:
そういった研究を高校生が・・・。すごいなぁ。。
津田:
放線菌の研究をしていた先生もいたりと、色々なつながりがありました。すごく環境がよかったと思っています。

ノーコードでAI開発に触れ、プログラミングにも興味を持ちました
HNL:
大学で引き続き、やってみたい研究活動はありますか?
津田:
Eyesを使ったことがきっかけで、自分でプログラミングできたらいいなと思うようになりました。本買って読んだりはしているところなんですよ。
Eyesを使わせてもらってきましたが、よいAIを作るための設定など、まだ目に見えないところが多いです。パラメータなどを理解できるようにするために、一度プログラミングを学んでみるのが一番いいのかな、と思っています。
HNL:
興味を持って勉強を始められることが一番良い流れですよね。素晴らしい!ちなみに、Eyesを使う前にAIを使ったことはありますか?
津田:
それが、全くなくて・・・。「AI」という言葉は聞いたことがあるんですが…。
AIというよりはプログラミングなどのようなことは中学生の時にやったことがありました。そのくらいです。
HNL:
Eyesを使ってみる前にAIについてどんな印象をもってましたか?
津田:
AIはプログラミングをして何かしている、というイメージはありました。AIは未知なもので、何をやっているかわからない、ただただすごいものという程度ですね。一番難しそうと感じていたのは、プログラミングです。意味がわからない配列で動いているものだな、という印象です。

HNL:
Eyesを使ってみてAIに関する印象は変わりましたか?
津田:
あそこまで簡単な形で整えていただいたら、使うのは簡単・・・、うーん、簡単とまではいきませんが、入門するときは絶対楽になると思いました。もっとよい精度のAIをつくるには、自分で知識をつけてパラメータを変えたりする必要はあるんですが、まず最初の入り口として、ちょっと触るだけでできるような形になっていることで、「AIをつかうのは結構簡単なんだ」と思いました。
とはいえ、触り始めてからが本番で、パラメータそれぞれがどんなものなのか、というところを調べるのが難しかったです。ただ、はじめて動画などで学んだりすることができたので、わかりやすかったです。
HNL:
パラメータのどんな部分が具体的に難しいという印象を持ちましたか?
津田:
何も調べていない状態だと、学習回数がなんなのかわからず、多ければ多いほど良いのかという考えからはじまりました。そこからちゃんと調べて、こうすればこうなる、というのが分かれば使いこなせるようになる感じはありました。使えば使うほどわかるようになって使いこなせて、うまく判別できるAIができるようになる印象です。ただ、データが集まりづらいものだと、精度をあげるのは結構難しいなと思いました。
HNL:
データを集めるのは大変ですよね。
津田:
あと、パラメータに何を指定したかがわからなくなる時がありました。
HNL:
パラメータはモデルの詳細ページにいくと、下の方の表に表示されているので、作ったモデルを消さなければ確認できるんですよね。モデルを消すと、作成した際のパラメータ情報も全て消えてしまいますが…。

HNL:
Eyesを知ったきっかけは何ですか?
津田:
Eyesのことを知る前は、画像解析を行うにはプログラミングを書かないといけないかな?と思っていたんです。当初は、クラスの中に画像解析をしているプログラミングに長けている人たちがいたので、その人に少し頼りながらやろうかな、と思っていました。
その頃に辻先生に教えていただきました。
僕の場合は、プログラミングよりもデータ数が少ないことの方が問題だったので、データを増やしながら自分でプログラミングを書く、というのは大変だなと感じていました。MSTでは大体、高校2年までが研究に取り組める期間です。知った時点であと2年くらいしかできない状態でした。短期間でやりたかったので、こんな簡単にできるのであればしっかり研究を進められるなと思いました。
HNL:
そもそも、画像でAIをつくろうと考えていたんですか?
津田:
培地を顕微鏡で観察した時にすごくいろいろな形があるなと思っていました。ぱっと見は白い丸なんですが、放線菌には放線菌特有の形があるということが、色々な本にのっていました。それだったら形で判別できるんじゃないかな?と思い、はじめてみた流れです。あと、先ほど話しましたが、同じクラスに画像解析をしている人たちがいたこともあり、組み合わせたらいけるのかな?と考えました。
実はこの研究を始める時に、最初はプログラミングをやりたいと思っていたんですが、三田国際学園には生物系に特化した研究環境があったので、せっかくだったらこの環境を使いたいと思ったんです。ただ、プログラミングなどの分野も面白そうだなとは思っていたので、合体できたら最高だなと思っていました。
HNL:
他に使ったサービスはありましたか?
津田:
AIに関してはないですね。10万行のデータの中から条件にあったデータを取り出すのにAnaconda(PythonおよびR言語の複数のパッケージを管理することができるプラットフォーム)を使ったりはしてました。
HNL:
一緒にEyesを使っている人はいましたか?
津田:
全く同じ研究をしている人と一緒に使っていました。二個下の後輩も同じ研究をする予定です。
HNL:
Eyesはどれくらいの頻度でつかっていましたか?
津田:
(高校)1〜2年生の頃は月一回はつかってました。研究発表の前はパラメータを変えて実行したりするため、頻度が多くなっていたと思います。
HNL:
津田くんの研究ではどんな作業を中心に行っていましたか?
津田:
主に放線菌の写真を撮り、写真をとったものの遺伝子を読んでいました。
写真を撮る方は結構進むんですが、遺伝子を読むのに2〜3週間くらいかかってしまうし、失敗もするので大変でした。
パラメータ設定は使いながら学んでいきました
HNL:
Eyesを使い始めた頃はどうでしたか?
津田:
本当に最初の段階では、何をすればいいのかがわからなかったので、先生に教えてもらいながら進めました。
最初の頃は、ひたすら四角い枠を作って(アノテーションして)学習する、を繰り返していました。ただ、予測結果を見ると、何の四角い枠もでなかった(見つけたい対象をみつけられなかった)ので、これは予測する時のパラメータの設定が重要なんだろうなと思い、先生に聞いたりしながら徐々に学んでいきました。
わからない頃は、学習回数や学習率を極端にあげたりしていましたが、ようやく最近になってコツがわかってきたかな?と思います。この辺を変えたらうまくいくのでは?というのを予想を立てながら、少しずつ使えるようになってきました。
使い方に関連する話なんですが、最初の頃はみつける対象を、放線菌かそれ以外か、で試していましたが、各微生物をみつける、というのもやってみようとなりました。はじめは、OK/NGなどの2択で分けると言う勝手なイメージがあったんですが、各微生物をAIに覚えさせることで、いろんな種類をみつけることができそうだと思って進めました。

HNL:
Eyesを使っていて困ったことはありますか?
津田:
たぶん、こう言う時に使いにくいところをいって欲しい、という意図で質問されたと思うんですが、僕は本当に使いやすいとおもっています。比較対象がないこともあるかもしれませんが、パラメータの調整も項目に分かれていて、複雑でもなく、これくらいなら調べて簡単に変更することもできるので、使い勝手はよかったです。そこで不便は感じませんでした。
HNL:
もう少し、こうだったらいいのになってところはありました?
津田:
ちょっと難しいかもしれないんですが、このパラメータを動かすとこうなるよ、のようなデータの例があると、わかりやすいかもしれないです。学習回数を上げるとどうなるのかというところがイメージしやすいといいなと思いました。調べればわかることだとは思うんですが。
HNL:
確かに、学習回数だけを変更した結果の例があるとわかりやすいかもしれませんね。
津田:
例えば、いちごではない対象で、ちょっと複雑な形で学習させるとどうなるのか?などがあるといいなと思いました。
最適な例は見つける対象や画像データによって変わるのでなんとも言えないと思うのですが、初心者向けに参考例があると、さらにわかりやすくなっていいなと思いました。
HNL:
確かに、いろんな方々に「何枚くらいあればAIできますか?」という質問を受けます。
この答えなのですが、学習する画像データがどんな画像か、見つけたい対象は何か、どんな状況で予測したいのか、精度はどのくらいを求めているのかによって全く変わるので、正直なところ「やってみないとわからない」というのが本音です。
とはいえ、「この画像データを使って、学習回数と学習率をこの値で学習すると、この予測結果になります」という例はあったほうが親切かもしれないですね。なんでうまくいかないのか?というところを、考えられるきっかけや例があると確かに想像しやすいな、と思いました。
辻:
7〜8割あっていれば使えるよね、のような感覚的なところがわかると、あたりをつけやすいですよね。
津田:
この回数だと過学習になってしまう、みたいなパターンなども、枚数によって変わってくるので、そういった情報もどこかでわかるといいなと思いました。
HNL:
大学に入ってもAIをつかっていきたいですか?
津田:
これから使わない手はないんだろうなと思ってます。やっていかないとこの先に繋がらないと思います。どういうところで使えるかというのもまだわかっていないけれど、絶対につかえるところはあると思っています。
HNL:
今回は貴重なお話をたくさん聞かせていただいてありがとうございました!大学でもぜひ研究を頑張ってくださいね!
Humanome Eyesは無料でお試しいただけます
Humanome Eyesは、商品検査や成熟度検査などの業務目的だけではなく、教育・研究用としても広くご利用いただけます。
本商品の購入、本商品に関するご質問・ご相談等につきましては、以下のフォームよりお気軽にお問い合わせ下さい。
ご相談はいつでも承ります

